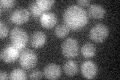
YLR047C
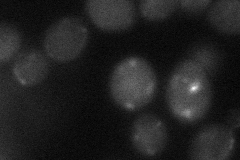
YLR047C

View description
Protein with sequence similarity to iron/copper reductases, involved in iron homeostasis; deletion mutant has iron deficiency/accumulation growth defects; expression increased in the absence of copper-responsive transcription factor Mac1p
Localization:
Intensity:
Fold change:
Significance:
-
C’ GFP library in SD
below threshold17.91 -
N' NOP1pr-GFP in SD

ER31.0771 -
N' TEF2pr-mCherry in SD

ER15.796 -
N' NATIVEpr-GFP in SD

below threshold15.8491 -
N' TEF2pr-VC and Cyto-VN in SD
below threshold25.0104 -
C’ GFP library in SD+DTT

cytosol21.421.19No -
C’ GFP library in SD+H2O2

cytosol23.681.32No -
C’ GFP library in Starvation Media

cytosol17.320.96No -
C’ GFP library on the background of Pup2-DaMP

below threshold -
C’ GFP library on the background of CCT mutant

below threshold18.13711.01219No
